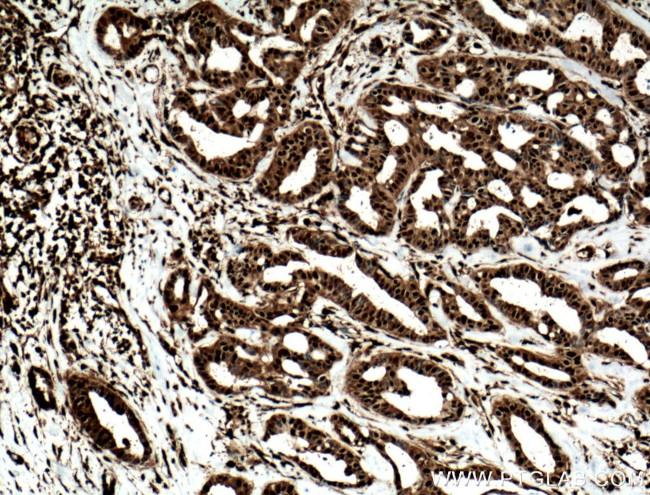
STAT5A Antibody in Immunohistochemistry (Paraffin) (IHC (P))

Search
Proteintech
STAT5A Polyclonal Antibody
{{$productOrderCtrl.translations['antibody.pdp.commerceCard.promotion.promotions']}}
{{$productOrderCtrl.translations['antibody.pdp.commerceCard.promotion.viewpromo']}}
{{$productOrderCtrl.translations['antibody.pdp.commerceCard.promotion.promocode']}}: {{promo.promoCode}} {{promo.promoTitle}} {{promo.promoDescription}}. {{$productOrderCtrl.translations['antibody.pdp.commerceCard.promotion.learnmore']}}
产品信息
13179-1-AP
种属反应
已发表种属
宿主/亚型
分类
类型
抗原
偶联物
形式
浓度
规格
纯化类型
保存液
内含物
保存条件
运输条件
产品详细信息
This antibody is a rabbit polyclonal antibody raised against residues near the C terminus of human STAT5A.
Immunogen sequence: ESQFSVGSN ELVFQVKTLS LPVVVIVHGS QDHNATATVL WDNAFAEPGR VPFAVPDKVL WPQLCEALNM KFKAEVQSNR GLTKENLVFL AQKLFNNSSS HLEDYSGLSV SWSQFNRENL PGWNYTFWQW FDGVMEVLKK HHKPHWNDGA ILGFVNKQQA HDLLINKPDG TFLLRFSDSE IGGITIAWKF DSPERNLWNL KPFTTRDFSI RSLADRLGDL SYLIYVFPDR PKDEVFSKYY TPVLAKAVDG YVKPQIKQVV PEFVNASADA GGSSATYMDQ APSPAVCPQA PYNMYPQNPD HVLDQDGEFD LDETMDVARH VEELLRRPMD SLDSRLSPPA GLFTSARGSL S (445-794 aa encoded by BC027036)
靶标信息
STAT5 alpha is a member of the STAT family of transcription factors. In response to cytokines and growth factors, STAT family members are phosphorylated by the receptor associated kinases, and then form homo- or heterodimers that translocate to the cell nucleus where they act as transcription activators. STAT5 alpha is activated by, and mediates the responses of many cell ligands, such as IL2, IL3, IL7 GM-CSF, erythropoietin, thrombopoietin, and different growth hormones. Activation of STAT5 alpha in myeloma and lymphoma associated with a TEL/JAK2 gene fusion is independent of cell stimulus and has been shown to be essential for the tumorigenesis. The mouse counterpart of STAT5 alpha is found to induce the expression of BCL2L1/BCL-X(L), which suggests the antiapoptotic function of this protein in cells. STAT5 alpha, along with STAT5 beta, were identified in mouse. The amino acid sequences of STAT5 alpha and STAT5 beta show 96% sequence similarity, and both proteins are co expressed in most tissues in virgin and lactating mice. However, differential accumulation of STAT5 alpha and STAT5 beta mRNA has been reported for both muscle and mammary tissue. STAT5 alpha is critically involved in a variety of physiological functions, including reproduction, lactation, immune function and somatic growth.
仅用于科研。不用于诊断过程。未经明确授权不得转售。
生物信息学
蛋白别名: epididymis secretory sperm binding protein; Mammary gland factor; mammary gland factor STAT5A; signal transducer and activator of transcription 5; Signal transducer and activator of transcription 5A; STAT; STAT5B; unnamed protein product
基因别名: AA959963; MGF; Mpf; STAT5; STAT5A
UniProt ID: (Human) P42229, (Rat) Q62771, (Mouse) P42230
Entrez Gene ID: (Human) 6776, (Rat) 24918, (Mouse) 20850